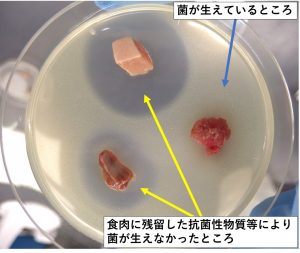
食肉中に残留する抗菌性物質等の簡易検査

と畜検査
新着情報
新着情報はありません。
と畜場法に基づき、食用に供する目的で搬入されたすべての家畜(牛、馬、豚、めん羊、山羊)※ について、と畜検査員(獣医師)が1頭ずつ検査しています。この検査に合格したものだけ、食肉として流通販売されることになります。
※いのししや鹿などの野生動物は含まれません。
- 検査の流れ
生体検査
と畜場に搬入された家畜の健康状態を検査します。異常を認め食用にできないと判断した場合はとさつを禁止します。
生体検査時に異常を認め、条件を付けてとさつを行った場合には、解体前検査を行います。
豚の生体検査
牛の生体検査
解体後検査
解体された家畜の内臓、枝肉、頭部について検査を行います。食用に適するか否か疑わしい場合には、一旦、保留とし、精密検査を実施します。
内臓検査
心臓、肺、肝臓、胃腸、リンパ節等について異常がないか調べます。
豚の内臓検査では、検査現場でタブレットに1頭ごとの検査データを入力しています。これらのデータは集計後、生産者等に還元しています。詳細はデータ還元事業のページをご覧ください。
枝肉検査・頭部検査
筋肉、腎臓、各種リンパ節、関節、骨、頭部などに異常がないかを調べます。
精密検査
解体後検査で異常を認め保留となったものについて、さらに詳細な検査を実施します。
微生物学的検査
心臓や肝臓などの主要臓器やリンパ節、筋肉などの細菌培養を行い、病原微生物が検出されないか検査します。
豚の膿毒症から分離されたTrueperella pyogenes
病理組織学的検査
血液や臓器の細胞や組織を顕微鏡で観察し、疾病の診断を行います。
牛伝染性リンパ腫 心臓の白色腫瘤のヘマトキシリン・エオジン染色(心筋に異型リンパ球が浸潤)
理化学的検査
血液や尿などを用いてBUNやビリルビン値の測定をして尿毒症や黄疸の診断を行います。また、食品衛生法に基づき、家畜の病気の予防や治療に使用される抗生物質等 ※ が食肉に残留していないか検査します。
※抗菌性物質等とは、抗生物質や合成抗菌剤、駆虫薬などを指します。
食肉中に抗菌性物質等が残留していない場合は培地全体に菌が生えますが、
残留している場合は食肉等の周囲に菌が生えない部分ができます。
高速液体クロマトグラフィー(LCMSMS)による残留抗菌性物質等の定性・定量
検印
検査に合格したものには1頭ずつ検印が押され、食肉として出荷されます。検印には、検査された「都道府県名」と「と畜場番号」が記されています。また、畜種によって形が定められています。
豚の検印
※ 検査の実績については、事業概要のページをご覧ください。
牛海綿状脳症(BSE)について
平成13年9月、国内で初めてBSEが確認されたことを受け、その対策として、肉骨粉を飼料として牛に与えることを禁止(飼料規制)するとともに、と畜場では異常プリオンがたまりやすいとされる特定部位を除去することとなりました。
こうした対策が徹底されたことから、BSEの発生はしだいに見られなくなり、平成25年5月には、国際獣疫事務局(OIE)に清浄国に認定されています。
<スクリーニング検査>
上記のBSE対策と併せて、すべての牛を対象としたスクリーニング検査を平成13年10月から平成25年6月まで実施しました。
その後、発生の減少に伴ってBSE対策の見直しともに検査の対象となる月齢も見直されてきました。
平成29年4月からは健康牛の検査は廃止され、24ヵ月齢以上の牛で、生体検査において神経症状が疑われるもの及び全身症状を呈するものが検査の対象となっています。
BSEについての詳細は、以下をご覧ください。
このページの掲載元
- 諫早食肉衛生検査所
-
郵便番号854-0022
長崎県諫早市幸町79番20号電話番号 0957-24-0934
ファックス番号 0957-24-4747